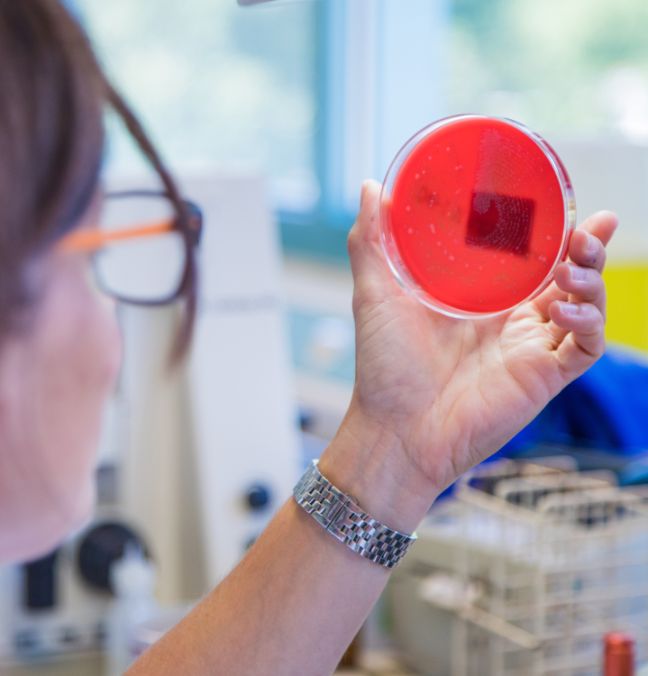

L’Ente Ospedaliero Cantonale è un ospedale pubblico polispecialistico, dotato di moderne infrastrutture e di una tecnologia medica all’avanguardia.
L’offerta sanitaria copre l’intero spettro della medicina moderna, con l’unica eccezione del trapianto d’organo. Le specialità cliniche sono assicurate e integrate nei vari presidi ospedalieri secondo una logica finalizzata ad armonizzare e ottimizzare il servizio sull’intero territorio cantonale, secondo il modello funzionale e dinamico dell’ospedale multisito.